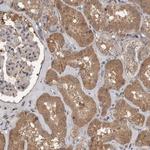
LLGL1 Antibody in Immunohistochemistry (Paraffin) (IHC (P))

Search
Invitrogen
LLGL1 Polyclonal Antibody
{{$productOrderCtrl.translations['antibody.pdp.commerceCard.promotion.promotions']}}
{{$productOrderCtrl.translations['antibody.pdp.commerceCard.promotion.viewpromo']}}
{{$productOrderCtrl.translations['antibody.pdp.commerceCard.promotion.promocode']}}: {{promo.promoCode}} {{promo.promoTitle}} {{promo.promoDescription}}. {{$productOrderCtrl.translations['antibody.pdp.commerceCard.promotion.learnmore']}}
产品信息
PA5-54827
宿主/亚型
分类
类型
抗原
偶联物
形式
浓度
保存条件
运输条件
RRID
产品详细信息
Immunogen sequence: STVVSSHSDG SYAVWSVDAG SFPTLQPTVA TTPYGPFPCK AINKILWRNC ESGGHFIIFS GGMPRASYG
Highest antigen sequence identity to the following orthologs: Mouse - 86%, Rat - 86%.
靶标信息
LLGL1 is a protein that is similar to a tumor suppressor in Drosophila. The protein is part of a cytoskeletal network and is associated with nonmuscle myosin II heavy chain and a kinase that specifically phosphorylates this protein at serine residues. The gene for LLGL1 is located within the Smith-Magenis syndrome region on chromosome 17.
仅用于科研。不用于诊断过程。未经明确授权不得转售。